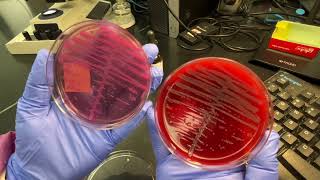

Auburn Community Hospital Laboratory Services: Accuracy video
Online izle ve mp4 mp3 formatlarinda yukle
Videonun muddeti: 0:57
Auburn Community Hospital Laboratory Services: Accuracy videosu mp4 ve mp3 yuklemek ucun hazirdir
Diqqet! Siz Mp4 yukle ve ya Mp3 yukle duymesine basdiqdan sonra eger sistem sizi reklam sehifesine atarsa o zaman derhal geri qayidib emeliyyati tekrar edin ve faylin yuklemek ucun hazir olmasini gozleyin
Videodan Mp4 Yukle
Videodan Mp3 Yukle-1
Videodan Mp3 Yukle-2
Oxshar Axtarishlar
Auburn Community Hospital Laboratory Services: Accuracy
Auburn Community Hospital Laboratory Services: Efficient
Auburn Community Hospital Laboratory Services: 70-Percent
Harnessing The Power of the Salinity h-series - The Auburn Community Hospital Experience
Testing Clinic in Auburn 12/30/20
Taking Action on Laboratory Developed Tests
Importance of Lab Tests
Testing Your Blood
Empowering Laboratory Professionals to Optimize Biomarker Testing
Video Mp4 Mp3Azwap.Biz
Azwap.Biz 2021-2023